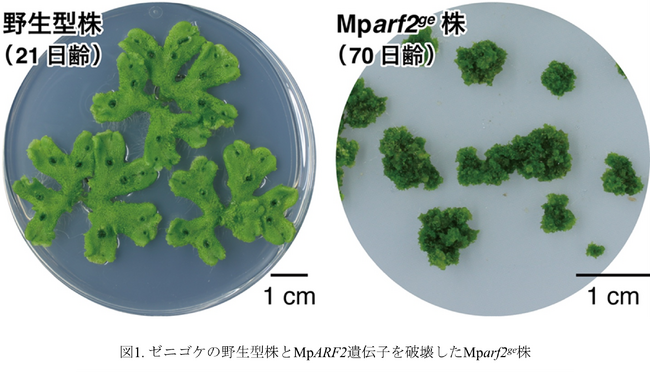

植物の永続的な成長を支える分子機構を解明 ~成長点の司令塔を担う転写因子が鍵~
配信日時: 2025-12-25 10:00:00
【研究の要旨とポイント】
コケ植物ゼニゴケを用いて、植物の無限成長を可能にするメカニズムを解明した。
植物ホルモンのオーキシンに応答する遺伝子の発現を抑制する転写因子MpARF2は、幹細胞領域とその周辺領域から構成される成長点の形成と維持に必須な働きをする。
MpARF2は幹細胞領域で高発現してオーキシン応答を抑える一方、オーキシン生合成酵素を活性化してオーキシンの生産を促す。
幹細胞領域で作られたオーキシンは、オーキシン輸送タンパク質によってその周辺領域に運ばれ、器官形成を促すシグナルとして働く。
幹細胞領域は、オーキシンを介して周辺領域の分化を指示しつつ、自身はその影響を受けないという、成長点の司令塔(オーガナイザー)として機能しており、MpARF2はその中核的な因子である。
【研究の概要】
東京理科大学 創域理工学部 生命生物科学科/総合研究院 生命のゆらぎ研究部門の西浜 竜一教授(元京都大学准教授)、同大学大学院 創域理工学研究科 生命生物科学専攻の今井 雄星元大学院生、京都大学大学院 生命科学研究科の河内 孝之教授、灰庭 瑛実元大学院生、木南 武元大学院生、東北大学 大学院生命科学研究科の鈴木 秀政助教(元京都大学大学院生)、帝京大学 先端機器分析センターの湯本 絵美技術職員、同大学 理工学部 総合理工学科/先端機器分析センターの朝比奈 雅志教授らは、モナシュ大学、ケンブリッジ大学と共同で、植物の幹細胞は分化を促進するホルモンを作るものの、自身はその影響を受けずに周辺で器官形成を促す成長点形成のしくみがあり、それが植物の永続的な成長の基盤となっていることを明らかにしました。本成果は植物の巧みな発生戦略と陸上植物の繁栄を導いた進化の一端を明らかにする発見であり、植物のサイズや形を自在に制御する技術の開発につながると期待されます。
植物は成長点(※1)に存在する幹細胞(※2)が未分化性を保ちながら分裂を続けることで、一生にわたり新しい器官をつくり続けます。本研究では、こうした無限成長(※3)のしくみをコケ植物(※4)のゼニゴケ(※5)を用いて明らかにしました。研究チームは、植物ホルモン「オーキシン(※6)」の作用を抑える転写因子 MpARF2(※7) に着目し、その機能を解析しました。その結果、MpARF2 は幹細胞領域で高く発現してオーキシン応答を抑える一方、オーキシン生合成酵素を活性化し、幹細胞自身がオーキシンを生産するしくみを支えていることが分かりました。生産されたオーキシンは周辺領域へ運ばれ、器官形成を促すシグナルとして働きます。つまり幹細胞領域は、周囲の細胞の分化を制御しつつ、自らはその影響を受けない司令塔(オーガナイザー)として機能しており、MpARF2 はその中核的な因子であることが明らかになりました。本成果は、植物の永続的な成長を支える基本原理の解明に大きく貢献するものです。
本研究成果は2025年12月6日(日本時間)にElsevier社が刊行する国際科学雑誌「Current Biology(電子版)」に掲載されました。
【研究の背景】
植物は、一生にわたって新しい葉や枝、根をつくり続けることができます。その源となっているのが、茎や根の先にある幹細胞です。幹細胞は未分化な状態を保ちながら分裂をくり返し、その周囲では細胞が分化してさまざまな器官が作られます。こうした発生を制御する重要な因子として、植物ホルモン「オーキシン」が知られています。オーキシンは細胞内で受容されると、ARFと呼ばれる転写因子を介して多くの遺伝子の発現を調節し、細胞の分化や器官形成を制御します。しかし、普段私たちが目にする被子植物ではオーキシン信号伝達を担う因子の数が増加しており、一つ一つの機能を調べることは困難でした。
そこで本研究ではコケ植物に注目しました。コケ植物は陸上植物が誕生して間もない約5億年前に維管束植物と分岐したグループで、なかでもゼニゴケはオーキシン信号伝達に必要な因子の最小セットをもつことから、発生のしくみや進化を理解するのに適しています。ゼニゴケも成長点に幹細胞領域をもち、そこが主要なオーキシン生合成の場であることが分かっていました。幹細胞は、分化促進ホルモンであるオーキシンを生産しながら、どのようにして未分化な状態を保っているのでしょうか。これは、植物発生の基本原理に関わる重要な未解決問題でした。
【研究結果の詳細】
研究チームは、ARFにはオーキシンに応答して遺伝子発現を促進するAクラス(ゼニゴケではMpARF1)と抑制するBクラス(MpARF2)があることに着目し、MpARF2遺伝子の機能解析を行いました。
まず、MpARF2がいつどこで働いているのかを調べました。その結果、MpARF2は未成熟な植物や傷ついて再生中の植物で将来幹細胞となる細胞で強く発現し、その後も継続的に働いていました。続いて、MpARF2の生体内での役割を調べるため、遺伝子機能を改変しました。MpARF2の機能を弱めると、植物の成長過程で幹細胞領域が徐々に消失し、最終的に成長が停止しました。このとき、幹細胞で働くはずの遺伝子(MpLAXR)が発現しなくなっていました。さらに、ゲノム編集技術を用いてMpARF2遺伝子を完全に破壊した株(Mparf2ge株)では、成長点を形成できず、未分化細胞や不完全に分化した器官が混在する細胞塊となりました(図1)。これらの結果から、MpARF2は幹細胞やその前駆細胞で働き、幹細胞の形成とその維持に不可欠な働きをしていることが明らかとなりました。
[画像1: https://prcdn.freetls.fastly.net/release_image/102047/213/102047-213-3487796930a480063d164b8b36ce0857-2150x1229.png?width=536&quality=85%2C75&format=jpeg&auto=webp&fit=bounds&bg-color=fff ]
続いて、MpARF2がオーキシン応答にどのように関与するのかを調べました。Mparf2ge株は外部からオーキシンを投与すると野生型株よりも顕著な成長阻害が見られ、オーキシンに対する感受性が高まっていることが分かりました。そこで、オーキシン処理後にRNA-seq解析を行い、遺伝子発現レベルでのオーキシン応答を調べました。野生型株ではオーキシン処理により発現が低下する遺伝子の方が多かったのに対し、Mparf2ge株では発現上昇する遺伝子が多く、発現変動の幅も大きくなっていました。さらに、両株の遺伝子発現を比較すると、Mparf2ge株では「オーキシンで発現上昇する遺伝子」はより高発現な状態に、「オーキシンで発現低下する遺伝子」はより低発現な状態になっており、オーキシン応答が全般的に強くなっていることが示されました。これらの結果から、MpARF2のオーキシン応答を抑制する役割が遺伝子発現レベルでも実証されました。
興味深いことに、RNA-seq解析の結果、Mparf2ge株ではMpYUC2という遺伝子の発現が低いことが分かりました。MpYUC2遺伝子はオーキシン生合成酵素をコードし、主に幹細胞領域で発現しています。詳細に調べると、MpYUC2の発現が広範囲化する条件下であっても、MpARF2の機能を弱めるとMpYUC2が発現する範囲は変化しませんでした。さらに、Mparf2ge株では野生型株よりも植物体内のオーキシン量が低下していました。これらの結果は、MpARF2がMpYUC2の発現を促してオーキシン生合成量を調節していることを示しています。
最後に、オーキシンがどこで作用しているのかを調べました。その結果、通常の条件ではオーキシンは幹細胞領域ではなく、その周辺領域で受容されていました。ところが、オーキシン輸送体をコードするMpPIN1遺伝子を破壊すると、周辺領域でのオーキシン受容が見られなくなりました。この結果から、幹細胞で生産されたオーキシンがMpPIN1によって周辺領域に運ばれて作用するという、空間的な役割分担が明らかとなりました。
以上を総合すると、次のような無限成長のしくみが明らかになりました(図2)。まず、オーキシンは幹細胞で生産された後、MpPIN1 によって周辺領域へ輸送されます。周辺領域ではオーキシン応答を促進するMpARF1が発現していることが知られており、細胞分化や器官形成を制御していると考えられます。このように多細胞にまたがる制御機構のなかで、幹細胞領域はオーキシンを生産して周辺領域の分化を指示しつつ自身はオーキシンに応答しない、いわば成長点の司令塔(オーガナイザー)として働きます。こうした幹細胞の機能は、幹細胞領域で高発現するMpARF2がオーキシン応答を抑制することで成り立っており、MpARF2は無限成長の要であるといえます。
[画像2: https://prcdn.freetls.fastly.net/release_image/102047/213/102047-213-77a43d44797b48d8b8d1d98e176d0480-1980x1645.png?width=536&quality=85%2C75&format=jpeg&auto=webp&fit=bounds&bg-color=fff ]
【今後の展望】
オーキシンによる遺伝子発現制御のしくみは陸上植物の祖先で確立されました。今回明らかになったMpARF2が幹細胞領域を成長点のオーガイザーとして機能させるしくみは、少なくともコケ植物の永続的な成長の基盤であると同時に、植物がさまざまな形態を進化させるうえで重要な役割を果たしたと考えられます。今後、このしくみがゼニゴケ以外の植物でも共通するのか、あるいはさらに別なかたちに変化しているのかを調べることで、植物の発生原理と多様性をより深く理解できると期待されます。
本研究で示された「幹細胞はシグナルを生み出すが、そのシグナルには応答しない」という原理は、植物の成長や形づくりを人為的に制御するうえで重要な視点です。長期的には、このようなしくみを応用することで、作物の成長点の強化や再生能力の制御など、農業やバイオテクノロジーへの展開も期待されます。
- 本研究は、Australian Research Council Centre of Excellence for Plant Success in Nature and Agriculture (CE200100015)、独立行政法人日本学術振興会(JSPS)特別研究員奨励費(課題番号:JP18J12698、JP20F19381)、JSPS研究活動スタート支援(課題番号: JP21K20649)、JSPS科研費若手研究(課題番号: JP24K18135)、新学術領域研究(課題番号: JP18H04836、JP20H04884、JP22H04733)の助成を受けて実施したものです。
【用語】
※1 成長点
植物体の先端に位置し、細胞分裂が活発な領域。メリステムとも呼ばれる。茎・葉・根などの器官はこの領域からつくられ、植物の成長と形づくりの中心的な役割を果たす。
※2 幹細胞
未分化な状態で自己複製し、必要に応じてさまざまな細胞に分化できる細胞。植物の幹細胞は成長点に局在し、新しい器官をつくるもととなる。
※3 無限成長
植物が一生を通じて新しい器官をつくり続ける性質。
※4 コケ植物
陸上植物の一グループで、苔(たい)類・蘚(せん)類・ツノゴケ類に細分される。陸上植物のなかで最も早く分岐したグループであり、植物の起源や発生のしくみを研究するうえで重要なモデルとなっている。
※5 ゼニゴケ
コケ植物の苔類に属する。学名Marchantia polymorpha。2017年に全ゲノムが解読され、実験室内での培養や遺伝子改変が容易などの理由から、研究モデルとして広く用いられている。
※6 オーキシン
植物ホルモンの一つ。植物がもつ天然オーキシンの代表はインドール-3-酢酸(IAA)。細胞分裂や器官形成、光や重力に対する屈性反応など、植物の成長や環境応答を調節する。
※7 ARF
オーキシンによる遺伝子発現制御を担う転写因子群。オーキシン応答性遺伝子をコードするゲノム領域に結合し、遺伝子の発現を促進または抑制する。植物種によっては多数のARFをもつが、ゼニゴケには3つだけ存在し、このうちMpARF1とMpARF2がオーキシン応答に関わる。
【論文情報】
[表1: https://prtimes.jp/data/corp/102047/table/213_1_65b996fc72351f1130921b50095b6c25.jpg?v=202512251115 ]
【発表者】
[表2: https://prtimes.jp/data/corp/102047/table/213_2_3538338593ec53312b912cf093341b67.jpg?v=202512251115 ]
【研究に関する問い合わせ先】
東京理科大学 創域理工学部 生命生物科学科 教授
西浜 竜一(にしはま りゅういち)
E-mail: nishihama【@】rs.tus.ac.jp
【報道・広報に関する問い合わせ先】
東京理科大学 経営企画部 広報課
TEL: 03-5228-8107 FAX: 03-3260-5823
E-mail: koho【@】admin.tus.ac.jp
京都大学 広報室広報課
TEL: 075-753-5729 FAX: 075-753-2094
Email: comms【@】mail2.adm.kyoto-u.ac.jp
東北大学 大学院生命科学研究科広報室
TEL: 022-217-6193 FAX: 022-217-5704
E-mail: lifsci-pr【@】grp.tohoku.ac.jp
帝京大学 本部広報課
TEL: 03-3964-4162 FAX: 03-3964-9189
E-mail: kouhou【@】teikyo-u.ac.jp
【@】は@にご変更ください。
※PR TIMESのシステムでは上付き・下付き文字や特殊文字等を使用できないため、正式な表記と異なる場合がございますのでご留意ください。正式な表記は、東京理科大学WEBページ(https://www.tus.ac.jp/today/archive/20251225_4712.html)をご参照ください。
PR TIMESプレスリリース詳細へ
スポンサードリンク
「東京理科大学」のプレスリリース
スポンサードリンク
最新のプレスリリース
- \総フォロワー数281万人/人気宅トレクリエイター「トレぴな」× FIXIT 共同開発!『MAKE BALANCE ソイプロテイン カフェラテ』を2026年5月11日より発売05/06 20:00
- 防犯専門誌「日防設ジャーナル」にChatlockが掲載--新製品発表を控え、日本市場での展開を強化05/06 17:45
- UNDPアフリカ局長が来日-アフリカ・日本の戦略的パートナーシップ強化へ05/06 16:59
- コード経験ゼロで業務時間を半分に--新恵社・AI Orchestra共催、非エンジニアのためのClaude Code入門ウェビナーを5月31日開催05/06 16:42
- ~医療費1兆円削減を目指す健康支援 “報道が少なくなった後”の被災地で実証へ~継続的な健康支援と地域インストラクター育成~05/06 16:20
- 最新のプレスリリースをもっと見る
